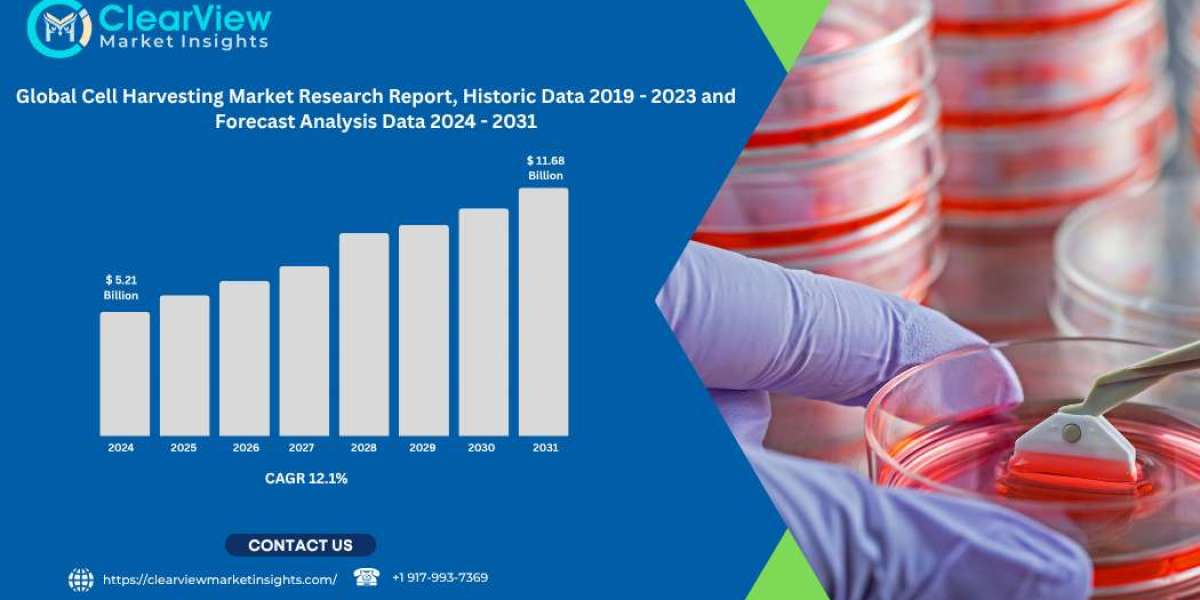

Global CBD Hemp Oil Market Expected to Exceed USD 18.37 Billion by 2031, Fueled by Wellness Trends and Regulatory Growth | #global CBD Hemp Oil Market


@bhavani
Global Cell Expansion Market to Surpass USD 44.6 Billion by 2031, Driven by Demand for Regenerative Medicine and Immunotherapies | #global Cell Expansion Market
Global Cell Harvesting Market to Exceed USD 11.68 Billion by 2031, Fueled by Growth in Cell Therapy and Biomanufacturing | #global Cell Harvesting Market
Global Cell Isolation Market to Reach USD 18.34 Billion by 2031, Driven by the Growth of Personalize | #cell Isolation Market
Global Chlamydia Infection Diagnostics Market to Reach USD 7.14 Billion by 2031, Fueled by Technological Advances and Expanding Screening Programs | #chlamydia Infection Diagnostics Market